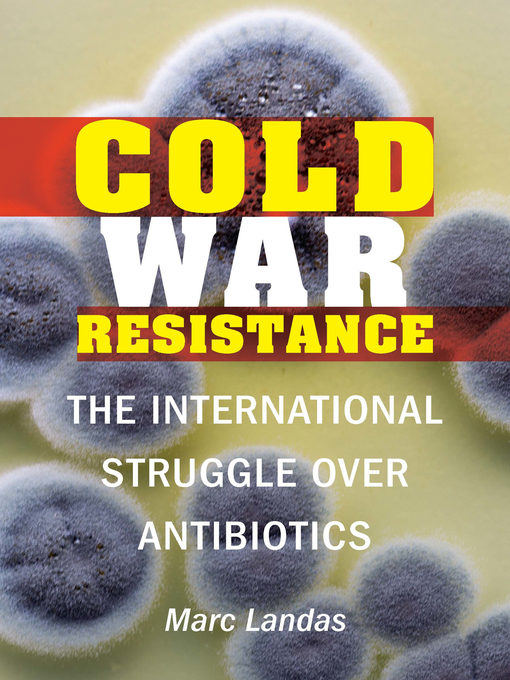
Title details for Cold War Resistance by Marc Landas - Available

- Newly Added eBooks - Available Now
- The Hit List (Books We Love)
- Top 500 eBook Fiction
- Top 500 eBook Nonfiction
- Popular Romance
- Books you may have missed
- Health & Fitness
- Business Biographies
- Fantasy
- Historical Fiction
- Thrillers
- Crime
- Self-Enrichment
- See all ebooks collections
- Newly Added Audiobooks - Available Now
- Top 500 Audiobook Fiction
- Top 500 Audiobook Nonfiction
- Business Biographies
- Business & Management
- Self-Enrichment
- Audiobooks for your commute
- Thrillers
- Foreign Language Study
- Humour
- See all audiobooks collections
- Newly Added
- Children’s Favorite Characters
- Most Popular Children's Titles
- Comic & Graphic Books
- Children's Read-Alongs
- Popular Teen Reads
- Armchair Explorers for Children and Teens
- Science Fiction & Fantasy - Available Now
- Roald Dahl Collection
- Popular eBooks
- See all children & teen collections
- Chinese Titles - Adult
- Chinese Titles - Young Adults
- Chinese Titles - Children's
- 中文书籍
- Malay Titles - Adults
- Malay Titles - Young Adults
- Malay Titles - Children's
- Tamil Titles
- Tamil Titles - Children's
- See all language collections collections